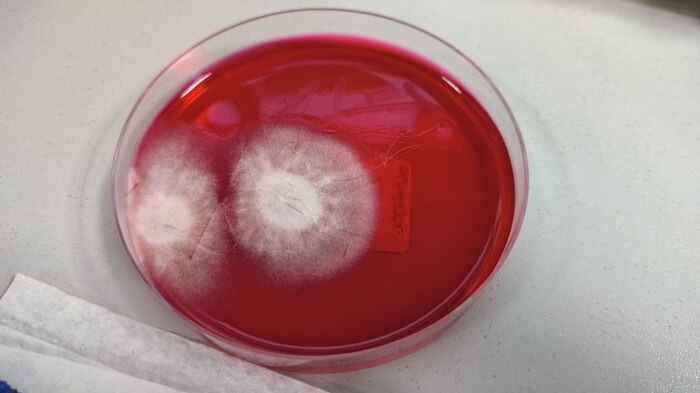

"Водопад" безопасности
На период описываемых событий пандемия COVID-19 стала обыденной частью жизни граждан.Люди без QR-кодов свободно могли перемещаться по улицам.Большинство уже вернулось на работу с "удаленок".Подавляющее количество населения к тому времени не носило маски,поясняя окружающим:"Я привился!".А если кто и носил,то на подбородке.
В нашей мед.организации уже отменили строгие правила по разделению потоков пациентов,желающих сдать ПЦР на "ковид" и тех,кто сдавал обычные анализы.
Противочумные костюмы мы уже не надевали,как и лицевые щитки.Однако по правилам,я всё равно ещё должна была сидеть в маске и перчатках.Поверхность стойки,на которую облокачивались посетители,изучая и подписывая договор(на оказание медицинских услуг),я всё так же дезинфицировала после каждого пациента.На дверях ещё красовалась табличка:" Вход без маски запрещен!".
Было послеобеденное время.Если и заходили редкие пациенты,то в основном за результатами анализов.
Все текущие рабочие дела были мною завершены и я сидела,таращилась в компьютер,изучая готовые исследования в базе с пометкой "патология".
Звякнул дверной колокольчик и подняв глаза я увидела женщину.
На голове у неё была шапочка для душа,на лице маска,а на маске защитный щиток.На руках у посетительницы были перчатки,натянутые на длинные рукава кофты.
Её внешний вид,несмотря на всеобщую "расслабуху", меня совсем не удивил.На тот момент я уже видела пациентов даже в противогазах.))
"Здравствуйте!" - поприветствовала я гостью.
Ничего мне не ответив,женщина подошла к стойке и выудила из сумки полуторалитровый распылитель зеленого цвета.Далее,посетительница так же молча,стала неистово орошать окружающее пространство и поверхность ресепшена.Нажимала она на рычаг пульверизатора,так активно,словно это - кистевой эспандер и время тренировки идёт на секунды.
Не обращая на меня никакого внимания гражданка нагнулась и продолжила обильно поливать тумбу стойки.
Я встала со стула,чтобы обратиться к ней,глядя в глаза.
- Женщина,что вы...
Договорить фразу я не успела.В этот момент посетительница резко выпрямилась и наставила на меня "дуло" опрыскивателя.
К сожалению,руководство так и не установило стекло на ресепшен,хоть и не раз обещало.
Целясь мне в лицо, "милая" женщина несколько раз,ритмично нажала на "спусковой крючок".
Огромное количество брызг на моих очках быстро соединилось в капли,которые начали стекать по стёклам.
- Что вы делаете?! -громко возмутилась я,выскакивая из-за стойки.
- У вас тут кругом микробы и зараза!Сколько больных людей тут проходит за день?!Кругом инфекция! - раздраженно ответила чудная бабенка.
На шум, из процедурного выбежала медсестра.
- У нас стоят рециркуляторы и всё обрабатывается согласно нормам СанПин! - законтрила я,снимая очки и поправляя намокшую челку. - Вы зачем мне лицо обрызгали?!
- Я имею право обезопасить себя!Я не знаю,как у вас тут,что обрабатывается и проконтролировать не могу! - выдала она повышая голос. - А на вас целый день больные дышат!Вы вся покрыты заразой!!!
С этими словами любительница стерильности до кучи обрызгала мне халат.
-Да хватит меня поливать! - требовательно повысила я голос,отпрыгивая назад.
Медсестре повезло,она благоразумно не подошла близко.
- Женщина,успокойтесь!Чего вы цирк устроили?!Кто дал вам право обливать окружающих?! -попыталась она воззвать к её здравому смыслу.
- Я имею право защищать себя! - сорвалась на крик дамочка. - Не надо рассказывать,что мне делать!
Я ощутила сильное желание вырвать у неё из рук распылитель и дать им ей по башке.
- Я собираюсь платить вам деньги за услуги.Вам деньги не нужны?!Перед этим я могу позаботиться о своей безопасности!Тоже мне,катастрофа...Это же не кислота.Я избавляю вас от бактерий!Лучше бы спасибо сказали! - не унималась женщина.
Маска на моём лице превратилась во влажную тряпку и я сняла её,чтобы протереть лицо и надеть новую.
- Что вы делаете?!Наденьте немедленно обратно!Вы не имеете права её снимать! - с ужасом заголосила пациентка,попятившись назад.
- Я не буду мокрая сидеть! - пояснила я,сдерживая раздражение.
- Что за шарага тут у вас?Это - бардак!Вы обязаны соблюдать правила!
Дамочка была близка к истерике и начала отступать к выходу.
- Я не буду у вас ничего сдавать! - "напугала" она. - Я буду жаловаться!Этот бордель нуждается в проверке!
С этими словами женщина вышла за дверь.
- Мдаааа! - очумевши подытожила я.
- Тебе повезло,что у неё был опрыскиватель,а не ведро! - хихикнула Марина.
"Грибной" дождик
Погода в тот день была отвратительная.
Дождь лил не переставая,с самого утра.На улице,где располагалось наше мед.учреждение,засорившиеся,древние ливневки не справлялись с количеством воды.Лужи на асфальте соединились в озера,заставляя людей балансировать на бордюрах,словно они - канатоходцы.
Мы с медсестрой стояли у входа,под козырьком,с наслаждением вдыхая влажный воздух(в рабочих помещениях он был высушен словно в пустыне).Я меланхолично разглядывала проезжающее по улице машины и редких людей,что пробирались по дорогам как эквилибристы.
Вдалеке мы заметили мужчину,сложно было не обратить на него внимание.
Во-первых, на нём были яркие резиновые сапоги цвета "морской волны",в которых он быстро и бодро вышагивал по затопленной дороге,словно поезд не имеющий альтернативы.
Во-вторых,зонтик,что он нёс над головой,был необычной расцветки,с узорами,напоминающими "бабкин халат".
Его сапоги проваливались под воду минимум по щиколотку,а ритмичные движение ног, создавали брызги летящие во все стороны.
- "Наш пациент"! - уверено сказала Марина.
- С чего ты взяла?
- Ж@пой чую. - вздохнула она.
И действительно.Стоило мужчине подойти ближе,он свернул с дороги к нам.
Мы зашли внутрь.Я села за ресепшен,готовая поприветствовать и обслужить пациента.Коллега встала рядом.
Мужик,лет 55 на вид, резко распахнул дверь,отряхивая на пол сложенный зонтик и потопал к нам.
- Добрый день!Чем могу помочь? - мило улыбнулась я.
В одной руке у мужчины был черный пакет.Сказав:"Здравствуйте!",он полез в него и выудил на свет трёхлитровую,стеклянную банку.
- Вот! - сказал он,поставив сосуд на ресепшен.
Посмотрев на содержимое,я ненадолго потеряла дар речи.
Пациенты часто приносили подобные банки на "суточный анализ мочи"(не зная как он правильно сдаётся в мед.учреждения).Если это был его анализ,то мне нужно было срочно вызывать "Скорую"!))
За стеклом находилась темно-коричневая жидкость,на поверхности которой плавала какая-то жуть.
Я в растерянности глянула на медсестру.
Марина стояла не чуть не удивленная,с какой-то странной улыбкой на лице,будто в предвкушении.
- Что ЭТО? - удивленно спросила я.
- На проверку принёс! -затараторил мужик. - Что-то не так!Он наверное болеет.
- Кто?! - встав со стула,я начала вглядываться в банку,пытаясь разглядеть какую-нибудь рыбку.
Люди иногда надеялись,что в нашей лаборатории есть отдел ветеринарии...
- Ну вот он сверху плавает. - указал заказчик исследований пальцем на поверхность. - Понимаете,он не растет! - добавил он с отчаянием.
- Кто "он"?! - не сдавалась я,не понимая,что происходит.
- Это - "чайный гриб"! - задорно подсказала мне Марина.
К моему стыду,про сей напиток,я только слышала.Но никогда не видела его в живую,даже по телевизору.
Оценив лицо мужчины на вменяемость,я попыталась объяснить ему,что подобными изучениями мы не занимаемся.
- Эм...Наша лаборатория специализируется на людях.Мы исследуем биоматериал на наличие болезней у людей!
- Но,вы всё-таки лаборатория!Значит у вас есть аппаратура,микроскопы!Вы же можете проверить.Я заплачу! - не сдавался мужик.
- К сожалению,мы не оказываем подобные услуги! - миролюбиво,но уверенно изрекла я.
- Но вы же можете глянуть в микроскоп.Вы же в этом понимаете!Сразу увидите,что не так!
Будь мы людьми,что зарабатывают "нечистыми" путями,на глупых и невменяемых людях,мужику мы бы "помогли".Взяли денег,забрали "болезного" и выявили бы какое-нибудь ОРВИ.))
К счастью,мы не относимся,к таким лицам.
- Простите,у нас нет специалистов,что занимаются изучением подобных "организмов". - я с интересом оглядела содержимое банки и странного посетителя.
- Что же мне делать?В ветеринарную лабораторию его отнести?Может вы знаете,где ближайшая? - с надеждой спросил мужик.
Мы переглянулись.
По виду Маринки,стало ясно - она сейчас согласиться с такой идеей.Любит она веселить людей.))
Мне мужчину стало жалко.Погода - "не лётная",а он носится с напитком.
- Не думаю,что там вам смогут помочь! - произнесла я с сочувствием.
- Вы не пробовали сахарку больше добавлять? - со знанием дела,вдруг спросила улыбчивая коллега.
- Я делаю всё как рассказали.Мне его подарили. - поведал любитель необычных напитков.
- Вы читали в интернете,как за ним ухаживать?Что делать,если не растет? - начала строго спрашивать Марина.
- Да,читал.
По его неуверенному ответу стало ясно - нет,не читал!
- Вы понимаете,я всё делаю вроде как надо!Я уже и так и эдак.Заряжаю его положительной энергетикой.Оно ведь знаете как!Любое живое существо - любит ласку и заботу.С растением поговоришь по-доброму,так оно растёт быстрее,выглядит лучше и плоды даёт вкуснее.Я ему даже имя дал...
Я поглядела на банку,которая судя по всему,заменяла мужчине "умную колонку".
К сожалению,как зовут "чайный гриб" я, так и не узнала...)Потому,что Марина мужчину перебила:
- Понимаю...Всё же рекомендую перечитать статьи по уходу в интернете. - уперто настояла она.
- Я перечитаю обязательно! - пообещал мужик,полностью переключив своё внимание на мою коллегу. - Всё же,мне кажется,что он заболел!
- Не исключено! - подтвердила медсестра,с максимально серьёзным лицом. - Если болеет,то к сожалению,медицина ещё не придумала методы лечения "чайного гриба".Возможно,в скором времени,ситуация измениться и будет осуществлен прорыв!Но когда это будет...
Я сидела и ощущала себя,словно в палате психиатрической больницы.Силы уходили на то,что бы не заржать.Выдержка коллеги впечатляла.))
- То есть,если он болеет - он умрет?! - искренне ужаснулся мужчина.
- Всё может быть... - философски изрекла Марина,глядя куда-то в даль.
Я начала перекладывать предметы на столе,пытаясь отвлечься и до боли закусила щеку.Даже заулыбаться в такой "скорбный" момент,было бы неправильно.))
- Что же делать? - спросил он,как-то риторически.
- Похоронить. - глухим голосом произнесла медсестра. - Когда придёт время.
Я напористо поглядела на неё,желая остановить её театральную постановку.Сдерживать смех,уже не было сил.Та,ещё сильнее издеваясь,посмотрела на меня со скорбью и развела руками.
Мужика было несомненно жалко.Так он любил свой гриб...
Решив перевести тему,я зачем-то брякнула:
- Может вам рыбок завести?
Одарив меня недобрым взглядом,мужчина сказал Марине от души: "Спасибо!" и затолкал "питомца" обратно,в пакет.
Когда дверь за ним закрылась,я повернулась к коллеге и вытирая слезы смеха,заявила:
- Ну ты и с@чка!
- Учись- как надо консультировать неадекватов! - гордо подняла она палец вверх!
- На кой,ты про "похороны"?
- Так смыть его в сортир,у него рука не поднимется! - весело подмигнула Марина.
Испуганный "пациент"
Рабочий день протекал как обычно,разве что беспрерывная очередь из желающих сдать анализы заставляла быстрее стучать по клавиатуре.
Одной из услуг лаборатории была возможность сдать иксодового клеща на проверку наличия в его мелком организме вируса энцефалита и бактерий боррелиоза.Исследование пользовалось популярностью.Разумные люди предпочитали выяснять возможные последствия укуса сразу,не дожидаясь симптомов.
В этот день,обеспокоенный мужчина принёс кровососущее насекомое на анализ,в не совсем обычной упаковке.На стойку ресепшн он положил старый напалечник из жесткой почти не прозрачной оранжевой резины.
Забирающая паразита медсестра,отворила затычку из ваты и изучила содержимое.Убедившись,что насекомое действительно клещ(перепуганные заказчики иногда приносили обычных жучков),она информировала меня:"Живой!".Данное обстоятельство указывается,при оформлении исследования, в разделе "примечания".
Из-за наличия большой очереди коллега решила "переселить" клеща в стандартную упаковку лаборатории позже.
Где-то через час,когда все пациенты нас покинули,я услышала из процедурного кабинета нецензурную брань.Меня как ответственного администратора привлекли звуки проблем и я зашла в кабинет.
Медсестра держала в руках напалечник и с растерянным видом оглядывала стол и полы.
- Сбежал!Нет его внутри! - объявила она с тревогой,демонстрируя пустую резинку.
- Как сбежал? - удивилась я.
- Видимо я вату плохо заправила!Через щель "утёк".
- Может он в самой вате заныкался?
- Нет,я её уже всю перепроверила. - в голосе Марины послышалось отчаяние.
Мне сразу представилось,как разожравшееся насекомое пробиралось через вату,к долгожданной свободе,словно Энди Дюфрейн по прорытому тоннелю(х/ф"Побег из Шоушенка").
Тревога передалась моментально и я так же начала искать смывшегося "пациента".Медсестра стала снимать и осматривать пробирки со стола и поверхность под ними.
- Ну и где эта тварь?! - негодовала коллега,поднимая предметы по третьему заходу.
- Не ссы найдём!Куда ему отсюда деться?Он же не блоха чтобы по-быстрому ускакать!
- А если нет? - нагнетала она - Надо будет звонить заказчику,извиняться и оформлять возврат денег.
- Что я этому мужику скажу?"У нас "побег"!Деньги мы вернём,но вы следите за своим самочувствием?!" - возмутилась я.Мне с трудом представлялся этот разговор и его последствия.
Ситуация складывалась максимально дебильная и неприятная.Мы уже предвкушали проблемы и разборки связанные с таким не стандартным эксцессом.
- С@ка членистоногая!!!Куда ты спрятался? - зло вопрошала медсестра. - Я тебя всё-равно найду мразота!Вылезай!
Будь я на месте "животины",точно бы забилась в самый темный и дальний угол.))
-Я его найду и грохну,скотину! -угрожала Марина. - Устроил мне диверсию.Только попадись!Попадись,пожалуйста! - сменила она гнев на милость. - Я тут!Вылазь,я вкусная!
Ожидаемо,на уговоры подлец не поддавался.
Пока коллега в очередной раз вглядывалась в кафель под столом,я подняла с дальнего края стола тяжелый аппарат"Центрифуга".
Пропавший кровосос к всеобщему облегчению нашелся под ней.
Пузатый,сытый клещ статично сидел.То расстояние,что он преодолел,впечатляло!Будь у него легкие,его бы мучала отдышка.))Проходить исследования,он явно был не настроен.Стоило поймать его в заготовленную "посуду",он протестующе задергал лапками.
Что ж..Пациенты часто боятся незнакомых исследований!))
- Заставил меня тут ползать,искать! - раздраженно предъявила медсестра беглецу,разглядывая его через прозрачный пластик. - Я тебе устрою карусель!
С этими словами она быстро затрясла контейнер,как шейкер,с оттенком удовлетворения на лице.
Вернувшись за стойку,я не сильно переживала за "пациента".Сдох он в итоге,от подобного "аттракциона" или в ужасе пытался вновь найти лазейку для побега?
Главное - инцидент был исчерпан и анализы ему сделали!
Носителем заболеваний,как оказалось он не был.По-этому видимо и пытался избежать не нужного ему медицинского вмешательства.)
Экскурсия
По лаборатории цветопрдбора.
Это мои любознательные подписчики, задают мне в чате вопросы, а потом, по мере возможности, я снимаю такие ролики. И увлекательно и познавательно на мой взгляд. Спасибо, вы делаете мой контент разнообразнее.
Ну и конечно мне прилетит от поклонников, если не будет мартышки. Это непозволительная наглость, так халтурить в своих выпусках.
Мне очень нравятся ваша реакция, вы делаете мой день ярче и жизнерадостней.





Мартышки
🔥 Видели как кипит краска в растворителе? Такое вы вряд-ли где-то ещё увидите 🔥
Я сняла уникальный эксперимент, где показываю, как краска ведёт себя в любимом малярами разбавителе, Р12.
Подписываться необязательно — просто заходите посмотреть. А возможно, вы захотите остаться со мной, ведь впереди у нас ещё больше интересных опытов. Рада каждой душе.
А на пикабу будут в основном мартышки, на канале их кстати нет, там я предельно серьёзна и строга ))
Спасибо Пикабу, ты делаешь меня счастливой.
В нашем деле опыт - равно - чуйка. С первого выкраса сложный цвет -это кайф
На самом деле, машина хоть и старенькая, но цвет очень сложный, прозрачный неукрывистый перламутр, перламутры они вообще капризные.
Но в нашем деле, главное все делать правильно, идти на ощупь, капнуть того, или этого, и смотреть, что же получается.
Это главный залог успеха, действовать изначально правильно, на интуиции порой, испортить дорогую краску, можно всегда успеть 😁
Когда я делаю такие сложные цвета с первого выкраса, я себя всегда хвалю.
Приходите на мой ТГ канал, он не коммерческий, я не рекламирую свои услуги, я просто общаюсь и рассказываю обо всём и ни о чём))) ну и там же отвечаю на любые вопросы ♥️ Всех обнимаю, нежно нежно, ваша Юлька.
Поиск работы
1.
Доброго дня! Меня зовут Дарья, Мне 20 лет, Рост 140 , Вес 35 -37кг.
Город Пермь. Живу на Репина .
Незнаю куда пойти работать.
Компьютерные курсы, Архивовед, Уборщица служебных помещений, Детскую поликлинику!?
Может место для меня найдётся.
Я трудолюбива.
2. С 13 июль - сентябрь 22, я работа в Геронтологическом центре. Бабулек дедушек подмывала. Уволили меня. Я себя не увольняла.
Второе место работы Бактериологическая Лаборатория Архангела Михаила. Уборщик Служебных помещений. Проработав там Месяц. Я неувольнялась, это меня уволили.
Про лишай
Всем привет! Рада, что многим интересна тема лабораторной диагностики и сегодня поговорим с вами о лишае или по-научному "Трихофитии".
У нас в лаборатории есть 2 теста для определения заражённых волос: посев шерсти на питательную среду и микроскопическое исследования пораженных волос.
Начнем с микроскопии.
Для исследования потребуется поражённая (на ваш взгляд) шерсть животного с мест облысения (алопецией), зажатая между двумя предметными стёклами и с вазелиновым маслом (ибо без масла под микроскопом мало что увидишь). Для того, чтобы определить пораженные волосы, можно воспользоваться лампой Вуда, под ее свечением пораженные волосы будут светиться) крипота:))
В лаборатории нам остаётся только изучить волосы под микроскопом и выдать заключение.
Вот так в одном поле зрения можно увидеть пораженные и здоровые волосы.
Приблизим пораженный участок:
Видно маленькие пузырьки: это и есть споры дерматофитов. Обнаружив такое, в заключении нам остаётся выдать информацию, что споры обнаружены, а уже владельцам с врачём думать, что с этим делать дальше. :)
А кто вообще такие - эти споры дерматофитов? По сути, это грибы :) 🍄 А грибы можно прорастить, если вы понимаете, о чем я...)
И вот тут мы подходим к более совершенному методу исследования - а именно к посеву шерсти на селективные среды для проращивания дерматофитов. В лабораторию поступает шерсть в контейнере, мы переносим её на среду, после чего среда помещается в термостат, где ей тепло и уютно расти :3. Смотрим за ростом среды в течении 21 дня. Каждые 3 дня врач проверяет рост и если появляется характерный рост, то эту среду мы забираем на микроскопию. Вникать в методику не буду, просто посмотрите, как выглядит подозрительный рост:
Видно, что от заразных волосков идет рост грибов, этакий стелющийся туман.
Вообще, есть 30+ видов грибов, но мы рассмотрим всего 3, наиболее распространенных, которые способны вызвать заражение животного. Посмотрим, как это выглядят под микроскопом. Искать будем макроконидии - зрелые формы спор. По методике, макроконидии можно увидеть под маслом или красителем. В данном случае применялся метиленовый синий.
Первый в очереди - Microsporum canis, встречается в 90% случаев. Напоминает вытянутое веретено с 4 и более делениями. На заднем фоне видны нити мицелия, макроконидии растут по ней, как листики по стеблю.🌿
А вот макроконидии под маслом. В данном случае к M.canis добавился M.gypseum (пузатые пирожки с 2-3 делениями). Редкая находка ;)
Есть ещё Trichophyton spp., но он нам ещё не встречался, поэтому ловите фото из интернета:
Источник инфекции M.canis - заражённые животные или контаминированные предметы. Человек тоже может подхватить эту заразу, поэтому не подозревая этого, можно стать Грутом, на котором растут "стебли и листики". 🌱 ...Так и дальше хочешь гладить бездомных кошечек?)) Он же такие ми-ми-ми)) 🐱
Это мы кстати ещё до паразитов не дошли...
На этом всё, спасибо за внимание!